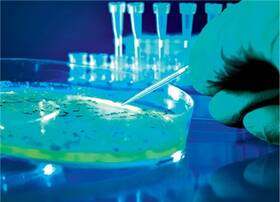

Eine der klinischen Herausforderungen liege demnach in der Diagnose. So gehe das Krankheitsbild mit vielen Symptomen einher, die auch bei anderen Infektionen der unteren Atemwege vorhanden sind: Fieber, Abgeschlagenheit, Husten mit oder ohne Auswurf sowie Dyspnoe und Desorientiertheit. Die im Vorjahr aktualisierte S3-Leitlinie empfiehlt daher zur Absicherung eine Röntgenthoraxaufnahme.
Wenn bei einem Patienten eine CAP diagnostiziert wurde, stellt sich die Frage, inwieweit er ambulant versorgt werden kann. »Der Schweregrad einer CAP wird mit dem sogenannten CRB-65-Score bestimmt«, informierte Pletz. C steht für mental Confusion (assoziierte Desorientierung), R für respiratory Rate (spontane Atemfrequenz ≥ 30 Atemzüge/min) und B für Blood Pressure (Blutdruck systolisch < 90 mm Hg oder diastolisch ≤ 60 mm Hg). Die Angabe 65 bezieht sich auf das Alter des Patienten (Alter ≥ 65 Ja oder Nein). Für jeden vorliegenden Parameter werde ein Punkt vergeben. »Je höher die Punktezahl, desto wahrscheinlicher wird die Krankenhauseinweisung«, sagte Pletz.
Die Leitlinie empfiehlt eine Therapie nach einer viergliedrigen Risikostratifizierung: ambulant behandelbare Patienten ohne und mit Komorbiditäten, Normalstation und Intensivstation. Patienten ohne Komorbiditäten sollten initial eine Monotherapie mit einem hoch dosierten Aminopenicillin-Präparat erhalten. Alternativ kann bei Penicillinallergie oder -unverträglichkeit ein Fluorchinolon wie Moxifloxacin oder Levofloxacin, nachgeordnet ein Makrolid (Azithromycin, Clarithromycin), oder ein Tetracyclin (Doxycyclin) gegeben werden. Liegen Komorbiditäten vor, sollen die Betroffenen initial ein hoch dosiertes perorales Aminopenicillin/ β-Lactamaseinhibitor-Präparat erhalten. Alternativ kann ein Fluorchinolon eingesetzt werden.
Bei Patienten mit mittelschwerer Erkrankung (Normalstation) sollte die antimikrobielle Therapie parenteral appliziert werden. Die Leitlinie empfiehlt Amoxicillin/Clavulansäure, Ampicillin/Sulbactam oder ein Cephalosporin der Klasse 2 oder 3a, gegebenenfalls mit einem Makrolid. »Werden bei klinischer Stabilisierung keine atypischen bakteriellen Erreger nachgewiesen, soll die begonnene Makrolidtherapie nach drei Tagen beendet werden«, ergänzte Pletz. Alternativ könne auch hier ein Fluorchinolon zum Einsatz kommen.
Auf der Intensivstation betreute Patienten sollen leitliniengerecht eine intravenöse Kombinationstherapie aus einem β-Lactam mit breitem Spektrum (Piperacillin/Tazobactam, Cefotaxim oder Ceftriaxon) und einem Makrolid erhalten. Alternativ könne eine Monotherapie mit einem Fluorchinolon begonnen werden, so der Referent. Dies gelte jedoch nur für Patienten ohne Schock.
Atypische Pneumonie
Vielfach werde übrigens noch der Ausdruck atypische Lungenentzündung für untypische Verläufe benutzt. Dieser sei aber veraltet, erklärte Pletz. Eine atypische Pneumonie ist definitionsgemäß durch untypische Erreger ausgelöst, also nicht Pneumokokken, sondern beispielsweise Legionellen.
»Die CAP ist eine Volkskrankheit, die ähnlich häufig vorkommt wie Schlaganfall oder Herzinfarkt.«